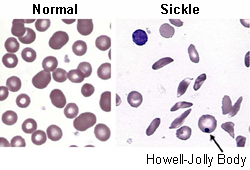
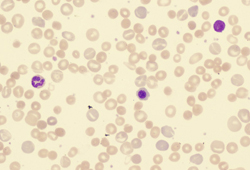

Images and videos
Images

Assessment of anaemia
CT scan of a ruptured abdominal aortic aneurysm
University of Michigan, specifically the cases of Dr Gilbert R. Upchurch reflecting the Departments of Vascular Surgery and Radiology
See this image in context in the following section/s:

Assessment of anaemia
Koilonychia
Reproduced with permission from Bickle Ian. Clinical exam skills: Hand signs BMJ 2004;329:0411402
See this image in context in the following section/s:
Assessment of anaemia
Red cells in sickle cell disease
From the personal collection of Sophie Lanzkron, MD; used with permission
See this image in context in the following section/s:

Assessment of anaemia
Megaloblastic macrocytic anaemia
From the collection of Dr Robert Zaiden; used with permission
See this image in context in the following section/s:

Assessment of anaemia
Peripheral blood film of a patient with acute myeloid leukaemia showing myeloid blasts with an Auer rod
From the collection of Dr Kavita Raj and Dr Priyanka Mehta; used with patient consent
See this image in context in the following section/s:

Assessment of anaemia
Chest x-ray showing a widened mediastinum
From the collection of Professor James Brown; used with permission
See this image in context in the following section/s:

Assessment of anaemia
Microcytic anaemia
From the collection of Dr Robert Zaiden; used with permission
See this image in context in the following section/s:

Assessment of anaemia
Angular cheilosis
Science Photo Library
See this image in context in the following section/s:

Assessment of anaemia
Cytospin prepared from bone marrow aspirate illustrates the typical cell cytology, with oval- to bean-shaped nuclei and moderate amounts of cytoplasm with irregular cytoplasmic borders (Wright Giemsa 100x oil)
From the collection of Lynn Moscinski, MD; used with permission
See this image in context in the following section/s:
Assessment of anaemia
Peripheral blood smear with spherocytes, reticulocytes, and a nucleated red blood cell (RBC)
From the collection of John Densmore, Department of Medicine, University of Virginia; used with permission
See this image in context in the following section/s:

Assessment of anaemia
Classification of anaemia: MCV, mean corpuscular volume; fL, femtolitres
Created by the BMJ Knowledge Centre
See this image in context in the following section/s:

Assessment of anaemia
Algorithm for the assessment of anaemia
Created by the BMJ Knowledge Centre
See this image in context in the following section/s:
Videos
- Venepuncture and phlebotomy animated demonstration
How to take a venous blood sample from the antecubital fossa using a vacuum needle.
Use of this content is subject to our disclaimer